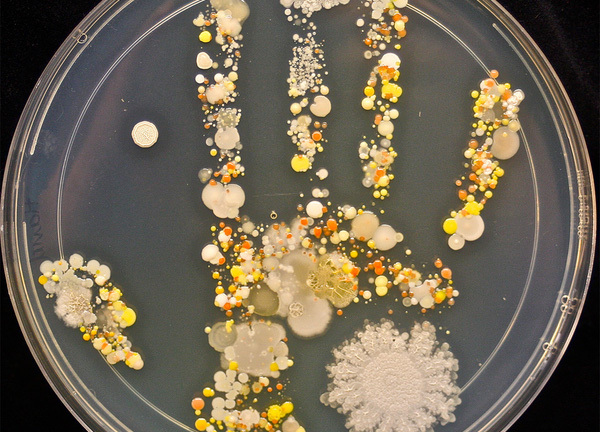
Mùa lạnh: Bị viêm phổi, tử vong chỉ vì... tay bẩn

Bác sĩ cho biết những trẻ thường xuyên bị viêm phổi và viêm phế quản rất có thể bị chứng lõm ngực bẩm sinh, cần điều trị ngay.
Tri thức trực tuyến đưa tin, các bác sĩ thuộc Trung tâm Tim mạch tại bệnh viện E (Hà Nội) vừa điều trị thành công cho hai bệnh nhân bị dị tật lõm ngực bẩm sinh.
Bệnh nhân T.V.L. (19 tuổi, ở Nam Định) thường xuyên phải nhập viện vì viêm phổi, viêm phế quản do lõm xương ức lệch phải từ nhỏ. Tuy nhiên, theo ông Trần Anh Tuấn, bố của bệnh nhân L., gia đình không hay biết về căn bệnh này, cho đến khi L. học lớp 8 và không thể tham gia các hoạt động thể thao hoặc làm các công việc nặng nhọc.
Các bác sĩ xác định bệnh nhân bị lõm ngực bẩm sinh thể II A3, và chỉ định phẫu thuật NUSS (đặt 2 thanh nâng ngực).
Bệnh nhân hồi phục sau khi được điều trị tại khoa Phẫu thuật Tim mạch và Lồng ngực, Trung tâm Tim mạch, bệnh viện E. Ảnh: Tri thức trực tuyến |
Bệnh nhân thứ hai là P.Q.M. (16 tuổi, ở Hải Phòng). Chị Đỗ Thị Xuân Hồng, mẹ bệnh nhân cho biết khi mới sinh, bé M phát triển bình thường, chỉ thỉnh thoảng cảm sốt nhẹ.
Từ đầu năm 2013 đến cuối năm 2014, M. đi học về luôn miệng kêu mệt mỏi, khó thở, thậm chí, thời gian gần đây, M. xuống cân rất nhanh, sức khỏe giảm sút rõ rệt và đặc biệt quan sát trên vùng ngực có một "hố" lõm ngày càng sâu, gia đình vội vàng đưa con tới viện.
"Đưa cháu đi khám mới biết đúng là con bị lõm ngực bẩm sinh. Lo cháu lớn lên sẽ ảnh hưởng đến sức khỏe nên gia đình tôi quyết định phẫu thuật cho cháu", chị Hồng chia sẻ.
Theo Tiền Phong, TS.BS Nguyễn Công Hựu – trưởng khoa Phẫu thuật tim mạch và lồng ngực, Trung tâm tim mạch, bệnh viện E cho hay: Lõm ngực bẩm sinh là bệnh lý hay gặp nhất (chiếm khoảng gần 90%) trong nhóm các bệnh biến dạng lồng ngực bẩm sinh ở trẻ em (lõm ngực, ngực dô kiểu ức gà, gù vẹo cột sống, khe hở xương ức…).
Với phương pháp phẫu thuật nội soi sử dụng thanh kim loại uốn cong đặt trong lồng ngực nâng bản xương lõm (phẫu thuật NUSS), chỉ với đường rạch nhỏ 2-3 cm phía sau hai bên thành ngực người bệnh, thời gian nằm viện ngắn. Cho đến khi xương phát triển ổn định (khoảng từ 2 đến 4 năm tùy tình trạng phát triển của xương) thì mổ lấy thanh nâng ngực ra.
TS Hựu cảnh báo khung lồng ngực bị biến dạng sẽ tác động đến các tạng bên trong. Những trường hợp lõm nhẹ thường ít bị ảnh hưởng. Khi trẻ bị lõm ngực nặng, tình trạng chèn ép gây ảnh hưởng đến chức năng 2 cơ quan quan trọng của cơ thể là tim mạch và hô hấp.
Bệnh nhi lõm ngực bẩm sinh kém phát triển thể chất. Các biểu hiện lâm sàng khác có thể gặp trong những trường hợp bị lõm nặng là trẻ nhanh mệt khi chơi các môn thể thao hay các hoạt động có tính chất gắng sức; thường xuyên mệt mỏi, hồi hộp; nhịp tim nhanh, tim lệch hẳn về bên trái khi bị chèn ép nhiều.
Đặc biệt, biến dạng lồng ngực ảnh hưởng xấu đến tâm sinh lý của người bệnh. Trẻ em thường sống khép mình, hạn chế các hoạt động xã hội, hạn chế trong giao tiếp, không dám tham gia các hoạt động thể thao có tính chất tập thể.
Chứng lõm ngực bẩm sinh ở trẻ em hoàn toàn có thể được chữa khỏi nhờ phẫu thuật - Ảnh: Sức khỏe và đời sống. |
Vì vậy TS Hựu khuyến cáo: Khi thấy trẻ có những bất thường vùng lồng ngực, cùng biểu hiện khó thở, mệt mỏi trong các hoạt động gắng sức, cần đưa đến bệnh viện chuyên khoa như Trung tâm tim mạch, bệnh viện E để được khám, phát hiện và xử lý kịp thời. Chụp cắt lớp lồng ngực là phương tiện chẩn đoán hình ảnh rất có giá trị, được sử dụng để đánh giá mức độ nặng của bệnh.
Ngoài ra còn giúp phẫu thuật viên đánh giá được hình thái lõm, mức độ cân xứng của lồng ngực, hình ảnh tim phổi, các thương tổn đi kèm, từ đó giúp phẫu thuật viên đưa ra các quyết định phẫu thuật hợp lý.
Bệnh nên được phẫu thuật ở trẻ em, tốt nhất ở lứa tuổi trước dậy thì khi lồng ngực đang còn phát triển sẽ cho kết quả tốt. Đối với tuổi trưởng thành, người lớn độ tuổi trung niên kết quả phẫu thuật cũng rất khả quan.
Tuy nhiên đối với người lớn do khung xương đã phát triển nên tỷ lệ bị lõm lại sau phẫu thuật cao hơn so với ở trẻ. Mùa hè khi trẻ được nghỉ học là thời điểm thuận lợi cho việc phẫu thuật nâng khung lồng ngực.
Minh Khôi(T/h)